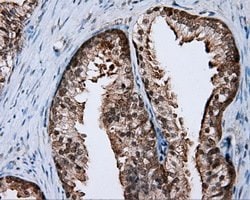
RALBP1 Mouse anti-Human, Clone: OTI6E8, lyophilized, TrueMAB 100 &mu;g;
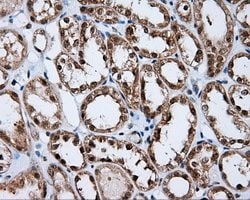
RALBP1 Mouse anti-Human, Clone: OTI6E8, lyophilized, TrueMAB 100 &mu;g;

Learn More
RALBP1 Mouse anti-Human, Clone: OTI6E8, lyophilized, TrueMAB™
Mouse Monoclonal Antibody
Brand: Origene Technologies CF500953

Description
Reconstitute with PBS (pH 7.3) and recommend to perform another round of desalting process using Product No. 7KMWCO
Can specifically activate hydrolysis of GTP bound to RAC1 and CDC42, but not RALA. Mediates ATP-dependent transport of S-(2,4-dinitrophenyl)-glutathione (DNP-SG) and doxorubicin (DOX) and is the major ATP-dependent transporter of glutathione conjugates of electrophiles (GS-E) and DOX in erythrocytes. Can catalyze transport of glutathione conjugates and xenobiotics, and may contribute to the multidrug resistance phenomenon. Serves as a scaffold protein that brings together proteins forming an endocytotic complex during interphase and also with CDC2 to switch off endocytosis, One of its substrates would be EPN1/Epsin.Specifications
| RALBP1 | |
| Monoclonal | |
| Unconjugated | |
| RALBP1 | |
| RIP1, RLIP1, RLIP76 | |
| Mouse | |
| Affinity Chromatography | |
| RUO | |
| 10928 | |
| -20° C, Avoid Freeze/Thaw Cycles | |
| Lyophilized |
| Immunocytochemistry, Immunofluorescence, Immunohistochemistry (Paraffin), Immunoprecipitation, Western Blot | |
| OTI6E8 | |
| PBS with 8% trehalose and no preservative; pH 7.3 | |
| Q15311 | |
| RALBP1 | |
| Full length human recombit protein of human RALBP1 produced in HEK293T cell. | |
| 100 μg | |
| Primary | |
| Human | |
| Antibody | |
| IgG1 |
The Fisher Scientific Encompass Program offers items which are not part of our distribution portfolio. These products typically do not have pictures or detailed descriptions. However, we are committed to improving your shopping experience. Please use the form below to provide feedback related to the content on this product.